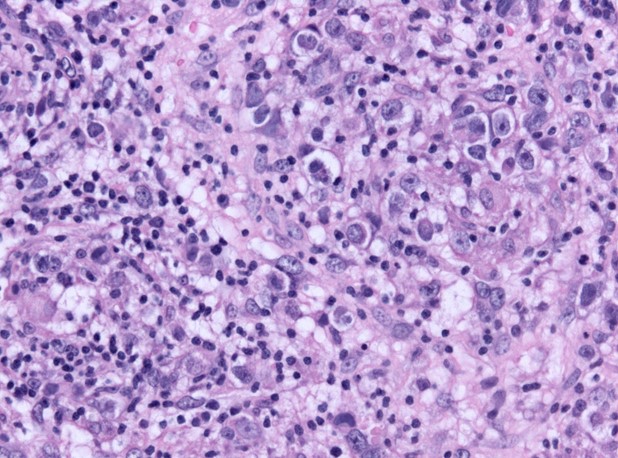

Study Confirms the Use of a New Biomarker for Predicting Non-Lymphocytic Lesions, Including Germinoma, in Patients with Central Diabetes Insipidus
Researchers show that patients with central diabetes insipidus who lack anti-rabphilin-3A antibodies could be at a higher risk of tumor development
Patients with central diabetes insipidus (CDI) experience excessive thirst and urine production due to decreased secretion of the antidiuretic hormone — arginine vasopressin (AVP). This rare condition presumably has multiple underlying causes. Furthermore, children and young individuals with CDI may develop “germinomas” at a later stage. A recent study by Japanese researchers highlights the value of assessing anti-rabphilin-3A antibodies as a means to predict germinomas in patients with CDI.
Central diabetes insipidus (CDI), a rare condition involving the destruction or degeneration of neurons of the hypothalamic-posterior pituitary in the brain, has several likely underlying clinical causes. Patients with CDI experience excessive thirst and excessive urine production, owing to the decreased secretion of AVP . Moreover, in children and young adults with CDI, a malignant tumor known as a 'germinoma' may develop later in life. The diagnosis of these tumors is challenging, because biopsy in intracranial lesions is difficult.
Lymphocytic infundibulo-neurohypophysitis (LINH) or inflammation of the pituitary, is often observed in patients with idiopathic CDI. A research team from Japan had previously suggested that LINH can be specifically diagnosed by examining the presence of anti-rabphilin-3A antibodies. Rabphilin-3A is a protein that is primarily found in the brain and is involved in some key neurological functions. As LINH and CDI are closely related, they speculated that patients with CDI who have these antibodies should be ideally free of germinomas. To validate their hypothesis, the researchers, led by Professor Yoshihisa Sugimura from the Department of Endocrinology, Diabetes and Metabolism, Fujita Health University, highlighted the effectiveness of measuring anti-rabphilin-3A antibodies for the prediction of germinomas in patients with CDI.
Their article was published in Hormones on September 11, 2023, and was co-authored by Haruki Fujisawa of Fujita Health University and Takako Takeuchi of Sapporo Medical University School of Medicine. “We summarized two very interesting case studies of patients with idiopathic CDI who lacked anti-rabphilin-3A antibodies and eventually developed germinomas,” says Prof. Sugimura.
The case reports involved a 13-year-old boy and a 19-year-old young man, both diagnosed with idiopathic CDI, with reduced hormone production from the gland. During the course of clinical investigations, blood samples were collected from both patients approximately 1 years and 6 months after the onset of CDI. The researchers looked for the presence of anti-rabphilin-3A antibodies in the blood/serum samples using Western blotting experiments. There were, however, no antibodies detected in either patient. Interestingly, both patients were diagnosed with germinomas within 15 months of CDI diagnosis and were successfully treated for the same. Prof. Sugimura remarks “These findings suggest that autoimmune mechanisms might not be involved here. Also, the timely assessment of anti-rabphilin-3A antibodies in the serum of patients with CDI is extremely important.”
Germinomas may occur in cases that show no or little abnormality in diagnostic imaging. Therefore, besides opting for regular imaging-based monitoring, the article also recommends testing for anti-rabphilin-3A antibodies, as their absence elevates the risk for the subsequent development of non-lymphocytic lesions, that include germinomas. “All patients with CDI must be carefully monitored to improve the clinical outcomes associated with non-lymphocytic lesions, including germinomas,” concludes Prof. Sugimura.
Kudos to the research team for identifying a new biomarker for promptly predicting reproductive cell tumors!
Patients with central diabetes insipidus (CDI) experience excessive thirst and urine production due to decreased secretion of the antidiuretic hormone — arginine vasopressin (AVP). This rare condition presumably has multiple underlying causes. Furthermore, children and young individuals with CDI may develop “germinomas” at a later stage. A recent study by Japanese researchers highlights the value of assessing anti-rabphilin-3A antibodies as a means to predict germinomas in patients with CDI.
Central diabetes insipidus (CDI), a rare condition involving the destruction or degeneration of neurons of the hypothalamic-posterior pituitary in the brain, has several likely underlying clinical causes. Patients with CDI experience excessive thirst and excessive urine production, owing to the decreased secretion of AVP . Moreover, in children and young adults with CDI, a malignant tumor known as a 'germinoma' may develop later in life. The diagnosis of these tumors is challenging, because biopsy in intracranial lesions is difficult.
Lymphocytic infundibulo-neurohypophysitis (LINH) or inflammation of the pituitary, is often observed in patients with idiopathic CDI. A research team from Japan had previously suggested that LINH can be specifically diagnosed by examining the presence of anti-rabphilin-3A antibodies. Rabphilin-3A is a protein that is primarily found in the brain and is involved in some key neurological functions. As LINH and CDI are closely related, they speculated that patients with CDI who have these antibodies should be ideally free of germinomas. To validate their hypothesis, the researchers, led by Professor Yoshihisa Sugimura from the Department of Endocrinology, Diabetes and Metabolism, Fujita Health University, highlighted the effectiveness of measuring anti-rabphilin-3A antibodies for the prediction of germinomas in patients with CDI.
Their article was published in Hormones on September 11, 2023, and was co-authored by Haruki Fujisawa of Fujita Health University and Takako Takeuchi of Sapporo Medical University School of Medicine. “We summarized two very interesting case studies of patients with idiopathic CDI who lacked anti-rabphilin-3A antibodies and eventually developed germinomas,” says Prof. Sugimura.
The case reports involved a 13-year-old boy and a 19-year-old young man, both diagnosed with idiopathic CDI, with reduced hormone production from the gland. During the course of clinical investigations, blood samples were collected from both patients approximately 1 years and 6 months after the onset of CDI. The researchers looked for the presence of anti-rabphilin-3A antibodies in the blood/serum samples using Western blotting experiments. There were, however, no antibodies detected in either patient. Interestingly, both patients were diagnosed with germinomas within 15 months of CDI diagnosis and were successfully treated for the same. Prof. Sugimura remarks “These findings suggest that autoimmune mechanisms might not be involved here. Also, the timely assessment of anti-rabphilin-3A antibodies in the serum of patients with CDI is extremely important.”
Germinomas may occur in cases that show no or little abnormality in diagnostic imaging. Therefore, besides opting for regular imaging-based monitoring, the article also recommends testing for anti-rabphilin-3A antibodies, as their absence elevates the risk for the subsequent development of non-lymphocytic lesions, that include germinomas. “All patients with CDI must be carefully monitored to improve the clinical outcomes associated with non-lymphocytic lesions, including germinomas,” concludes Prof. Sugimura.
Kudos to the research team for identifying a new biomarker for promptly predicting reproductive cell tumors!
Title of original paper
Absence of anti-rabphilin‑3A antibodies in children and young adults with idiopathic central diabetes insipidus: a potential clue to elucidating a tumor etiologyJournal
HormonesDOI
https://doi.org/10.1007/s42000-023-00484-0
Image Title: New antibody-based biomarker for the prediction reproductive cell tumors in patients with central diabetes insipidus
Image Caption: Microscopic image reveals the presence of germinomas in a clinical sample of central diabetes insipidus
Image Credit: "Germinoma he x200" by Jensflorian from Wikimedia Commons
Image Source Link to be added in the Image Credit Section of EA form:here
License type: CC BY-SA 3.0
About Professor Yoshihisa Sugimura
Yoshihisa Sugimura works as a Professor at the Department of Endocrinology, Diabetes and Metabolism, Fujita Health University, Japan. His research group primarily focuses on central diabetes insipidus, rabphilin‑3A, arginine vasopressin, autoimmune hypophisitis, hyponatremia, neuronal function, and demyelinating diseases. Dr. Sugimura has over 85 publications to his credit, including those published in the Journal of the American Society of Nephrology and The Journal of Clinical Endocrinology and Metabolism. He has also authored more than 20 books on a wide variety of research topics.
